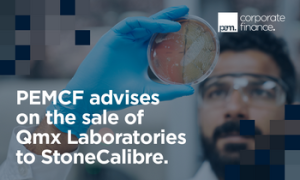

Budget worries knock business confidence in the region
Concerns amongst firms over potential tax rises and other measures which may feature in the autumn Budget appear to have shaken business confidence in the region and dented hiring intentions. A business barometer from Lloyds Bank Commercial Banking showed that business confidence in the East of England fell by 30 points during September to 22 per cent, its lowest level for 18 months and down from 52 pc in August. Kirsty Sadler, regional director for the East of England, Lloyds Bank Commercial Banking, said: “While this fall in confidence may come as a shock during harvest season, with agriculture continuing to be a key regional industry, we may be seeing the impact of reports that the upcoming Budget is set to be challenging.” Companies in the East reported lower confidence in both their own business prospects, down 21 points at 39 pc, and their optimism in the economy, down 38 points to 6pc. Meanwhile, a net balance of just 10 pc of businesses in the region expect to increase staff levels over the next year, down 17 points on August. Kirsty Sadler added: “But looking ahead, it’s encouraging to see that investing in their teams, including measures like improving training, is still a priority for businesses in the coming months.”
Nationally, overall UK business confidence in September dipped slightly and there was a marginal increase in firms’ own trading prospects. Hann-Ju Ho, senior economist at the bank, said: “The more mixed picture for economic optimism points to some businesses maintaining a degree of caution. While we still expect economic expansion, it may occur at a slower rate than the first half of 2024.”
Briefly…
Suffolk brewer plans to rebuild facility to process food waste

Southwold-based brewer and hospitality group Adnams is seeking to rebuild its anaerobic digestion facility in nearby Reydon in a partnership with Bio Capital, a provider of sustainable energy solutions. The redevelopment of a facility built in 2010 would see it in service ahead of new legislation set to require local authorities to collect food waste separately from all households. Suffolk currently lacks a dedicated facility to process food waste through anaerobic digestion and the initiative aims to fill the void. Adnams CEO Jenny Hanlon said: “A new AD facility at our Reydon site would become a cornerstone of Suffolk’s wider sustainability efforts and will integrate seamlessly with future waste regulations, providing a solution for food waste recycling and renewable energy production. It will have long-term benefits for the local economy by creating new job opportunities, and positioning Suffolk as a leader in the renewable energy sector.” Open consultations on the plans will be held Tuesday 8th and Wednesday 9th October, at Southwold Arts Centre.
Suffolk Chamber members named as regional winners in national awards
Two Suffolk Chamber of Commerce members have been named as regional winners in the British Chamber Business Awards 2024. Precision farming technology company Claydon Yield-O-Meter has been awarded Global Britain Business of the Year in recognition of its contribution to exports and its pioneering approach to agricultural innovation. Frugalpac, which produces sustainable packaging solutions, won the Green Innovation Business of the Year award for its commitment to sustainability and groundbreaking work in developing environmentally-friendly packaging. Suffolk Chamber chief executive John Dugmore said: “….These awards not only recognise their innovative contributions but also showcase the strength and diversity of the business community here in Suffolk. We wish them the best of luck as they move on to the national stage.”
Essex-based specialist chemicals provider sold to global group
Qmx Laboratories, a leading provider of specialist chemicals and products to research and quality testing laboratories which is based in Thaxted, Essex has been sold to Calibre Scientific, a global supplier in the life sciences sector. PEM Corporate Finance acted as lead adviser to Qmx Laboratories which is a leading supplier of reference standards and materials. Founded in 2013, Calibre Scientific is a diversified global provider of life science reagents, tools, instruments, and other consumables to the lab research, diagnostics, industrial, and biopharma sectors. Philip Olagunju and Darren Hagan from PEMCF assisted the vendors with price negotiations, net working capital analysis, due diligence assistance and general transaction support. Dr Glyn Banks, managing director and founder of Qmx Laboratories, said: “PEMCF have been a reassuring guide through the process providing pertinent professional advice with a friendly, supportive manner, ensuring a successful outcome. Philip and his team have been approachable and relatable throughout and have been a pleasure to work with. The new partnership between Qmx Laboratories and Calibre Scientific will provide the resources and support to enable the continued growth of Qmx Laboratories whilst ensuring the high standards of customer service and technical expertise are maintained.” Legal advice to the vendor was provided by Alastair Gunn and Martino Barzaghi of Buckles Law.
See Profile PEM Corporate Finance
Insurance group appoints new apprentices to Norwich hq

Insurance broker and financial planners Alan Boswell Group has appointed seven new apprentices to its Norwich head office. They will work towards the level 3 insurance practitioner – junior broker apprenticeship and will work across different departments, gaining experience and insight into the industry and benefitting from the experience of the group’s 400-strong employees. The group’s apprenticeship scheme was launched in 2010 and of those who have completed the scheme, 24 still work for the group. Gillian Anderson Brown, HR director at the group, said: “Our apprenticeship scheme has always been an important part of our commitment to developing young talent and giving them the opportunity to learn and grow within the insurance sector. We look forward to supporting these apprentices as they begin their careers with us.”
See Profile Alan Boswell Group
Trading rebounds at garden centre group

Garden centre group Notcutts has reported higher annual turnover; up by 4.1 per cent to £78.6m with an operating profit up at £1.6m. Chief executive Nick Burrows (right) said: “Trading has begun to rebound, and we believe it will continue to do so as economic conditions improve.” He added: “We have continued with our programme to develop our garden centre portfolio in order to support the ongoing prospects of the business. This has included the completion of our project to restore the historic Edwardian Messenger glasshouses at our Dukeries garden centre near Worksop; the expansion of our restaurant capacities in Oxford, Tunbridge Wells, Wheatcroft (Nottingham) and Norwich; and a solar power installation in Woodbridge. We have also made significant investments in our IT infrastructure with new retail, stock management and CRM systems during the year which will bring exciting new efficiencies and opportunities for our business.”
Growing Essex law firm makes new appointments

Essex law firm Thompson Smith and Puxon has appointed specialist commercial property solicitor Joanne Kelly (right) as a director in its commercial property team. The appointment takes the number of directors to 13 and comes during a period of record growth for the firm. Based in the firm’s Colchester office, she brings 30 years of experience across a wide area of commercial real estate matters and joins from a sliver circle firm. Chief executive officer Sean Stuttaford said: “…The addition of Joanne further strengthens our ability to provide comprehensive legal solutions tailored to the needs of our diverse client base, particularly our agribusiness and commercial property connections. This appointment is a clear reflection of our focus on growth and our determination to keep up with demand for our specialist knowledge and commercial insight.” Thompson Smith and Puxon has also appointed Ann Coutts as a senior associate in the firm’s award-nominated wills & estates team. Based in TSP’s Colchester office, she has spent the last 19 years specialising in private client law; undertaking all areas but concentrating on supporting HNW clients with lifetime tax planning and inheritance tax planning. She is one of four appointments in the team reflecting growing demand for its expertise with new associate chartered legal executive Carlie Brown and two new legal secretaries also joining.
See Profile Thompson Smith & Puxon
Resort sponsors initiative to encourage event agencies on sustainability

Wyboston Lakes Resort, which has won awards for its sustainability innovations, is encouraging event agencies on their sustainability journey while gaining recognition for their actions. The resort, west of Cambridge, is sponsoring the Power 50 – the UK’s Top 50 Most Sustainable Event Agencies, which has been launched by event:decision in partnership with micebook. Louisa Watson, marketing director and sustainability lead at Wyboston Lakes Resort, said: “Our total commitment to sustainability is reflected by our pledge ‘More Sustainable, No Apology’ and that includes encouraging the whole of our industry to work continually to make events more sustainable. This new initiative by event:decision and micebook will give well deserved recognition to agencies that are already working very hard at this and it should encourage everyone to increase their efforts.” Agencies throughout the UK involved in the creation and staging of events of all types are invited to enter. Entries will be objectively scored and will be announced at micebook Expo in January 2025.